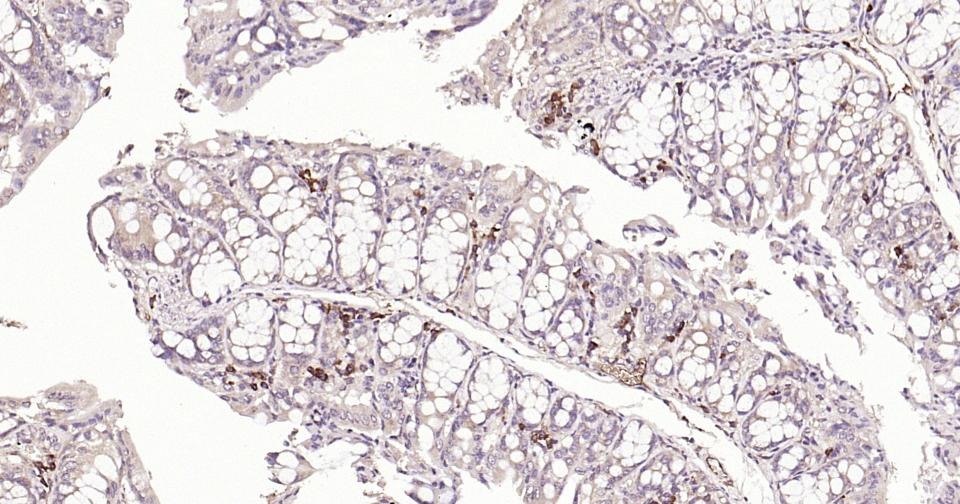
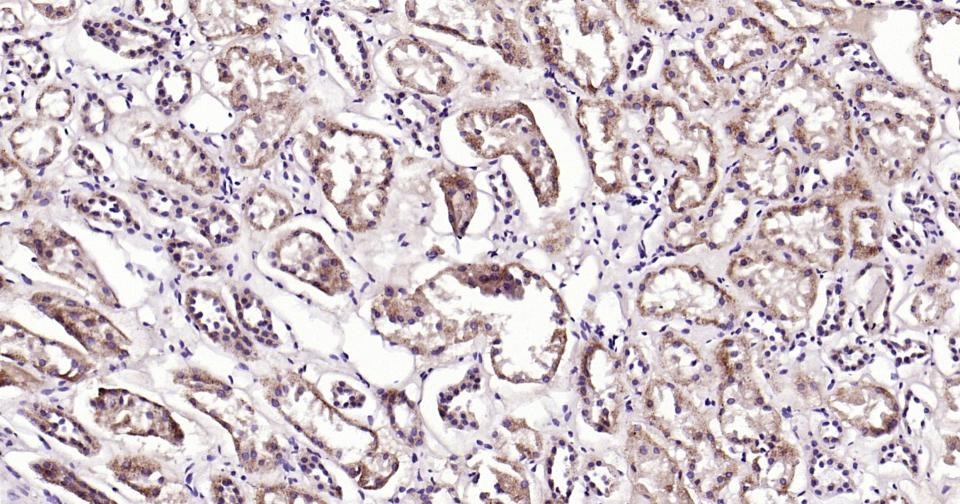

购物车
 您的购物车当前为空
您的购物车当前为空
Anti-Beclin-1 Antibody (8U829) 是一种 Mouse 抗体,靶向 Beclin-1。Anti-Beclin-1 Antibody (8U829) 可用于 IF,IHC-Fr,IHC-P。
别名 Protein GT197, GT197, Coiled-coil myosin-like BCL2-interacting protein, BECN1, Beclin-1
Anti-Beclin-1 Antibody (8U829) 是一种 Mouse 抗体,靶向 Beclin-1。Anti-Beclin-1 Antibody (8U829) 可用于 IF,IHC-Fr,IHC-P。
| 规格 | 价格 | 库存 | 数量 |
|---|---|---|---|
| 50 μL | ¥ 1,160 | 5日内发货 | |
| 100 μL | ¥ 1,975 | 5日内发货 | |
| 200 μL | ¥ 2,790 | 5日内发货 |
TargetMol的所有产品仅用作科学研究或药证申报,不能被用于人体,我们不向个人提供产品和服务。请您遵守承诺用途,不得违反法律法规规定用于任何其他用途。
| 产品描述 | Anti-Beclin-1 Antibody (8U829) is a Mouse antibody targeting Beclin-1. Anti-Beclin-1 Antibody (8U829) can be used in IF,IHC-Fr,IHC-P. |
| 别名 | Protein GT197, GT197, Coiled-coil myosin-like BCL2-interacting protein, BECN1, Beclin-1 |
| Ig Type | IgG |
| 克隆号 | 8U829 |
| 反应种属 | Human,Mouse,Rat |
| 验证活性 | 1. Paraformaldehyde-fixed, paraffin embedded Mouse Colon; Antigen retrieval by boiling in sodium citrate buffer (pH6.0) for 15 min; Antibody incubation with Beclin 1 Monoclonal Antibody, Unconjugated (ascites of TMAB-00208) at 1:200 overnight at 4°C, followed by conjugation to the secondary antibody and DAb staining. 2. Paraformaldehyde-fixed, paraffin embedded Rat Colon; Antigen retrieval by boiling in sodium citrate buffer (pH6.0) for 15 min; Antibody incubation with Beclin 1 Monoclonal Antibody, Unconjugated (ascites of TMAB-00208) at 1:200 overnight at 4°C, followed by conjugation to the secondary antibody and DAB staining. 3. Paraformaldehyde-fixed, paraffin embedded Human Colon; Antigen retrieval by boiling in sodium citrate buffer (pH6.0) for 15 min; Antibody incubation with Beclin 1 Monoclonal Antibody, Unconjugated (ascites of TMAB-00208) at 1:200 overnight at 4°C, followed by conjugation to the secondary antibody and DAB staining. 4. Paraformaldehyde-fixed, paraffin embedded Mouse Spleen; Antigen retrieval by boiling in sodium citrate buffer (pH6.0) for 15 min; Antibody incubation with Beclin 1 Monoclonal Antibody, Unconjugated (ascites of TMAB-00208) at 1:200 overnight at 4°C, followed by conjugation to the secondary antibody and DAB staining. 5. Paraformaldehyde-fixed, paraffin embedded Rat Spleen; Antigen retrieval by boiling in sodium citrate buffer (pH6.0) for 15 min; Antibody incubation with Beclin 1 Monoclonal Antibody, Unconjugated (ascites of TMAB-00208) at 1:200 overnight at 4°C, followed by conjugation to the secondary antibody and DAB staining. 6. Paraformaldehyde-fixed, paraffin embedded Mouse Kidney; Antigen retrieval by boiling in sodium citrate buffer (pH6.0) for 15 min; Antibody incubation with Beclin 1 Monoclonal Antibody, Unconjugated (ascites of TMAB-00208) at 1:200 overnight at 4°C, followed by conjugation to the secondary antibody and DAB staining. 7. Paraformaldehyde-fixed, paraffin embedded Human Kidney; Antigen retrieval by boiling in sodium citrate buffer (pH6.0) for 15 min; Antibody incubation with Beclin 1 Monoclonal Antibody, Unconjugated (ascites of TMAB-00208) at 1:200 overnight at 4°C, followed by conjugation to the secondary antibody and DAB staining. 8. Paraformaldehyde-fixed, paraffin embedded Rat Cerebrum; Antigen retrieval by boiling in sodium citrate buffer (pH6.0) for 15 min; Antibody incubation with Beclin 1 Monoclonal Antibody, Unconjugated (ascites of TMAB-00208) at 1:200 overnight at 4°C, followed by conjugation to the secondary antibody and DAB staining. 9. Paraformaldehyde-fixed, paraffin embedded Mouse Cerebrum; Antigen retrieval by boiling in sodium citrate buffer (pH6.0) for 15 min; Antibody incubation with Beclin 1 Monoclonal Antibody, Unconjugated (ascites of TMAB-00208) at 1:200 overnight at 4°C, followed by conjugation to the secondary antibody and DAB staining. 10. Paraformaldehyde-fixed, paraffin embedded Rat Stomach; Antigen retrieval by boiling in sodium citrate buffer (pH6.0) for 15 min; Antibody incubation with Beclin 1 Monoclonal Antibody, Unconjugated (ascites of TMAB-00208) at 1:200 overnight at 4°C, followed by conjugation to the secondary antibody and DAB staining. 11. Paraformaldehyde-fixed, paraffin embedded Human Fundus; Antigen retrieval by boiling in sodium citrate buffer (pH6.0) for 15 min; Antibody incubation with Beclin 1 Monoclonal Antibody, Unconjugated (ascites of TMAB-00208) at 1:200 overnight at 4°C, followed by conjugation to the secondary antibody and DAB staining. 12. Paraformaldehyde-fixed, paraffin embedded Human Cervical Cancer; Antigen retrieval by boiling in sodium citrate buffer (pH6.0) for 15 min; Antibody incubation with Beclin 1 Monoclonal Antibody, Unconjugated (ascites of TMAB-00208) at 1:200 overnight at 4°C, followed by conjugation to the secondary antibody and DAB staining. |
| 应用 | IFIHC-FrIHC-P |
| 推荐剂量 | IHC-P: 1:100-500; IHC-Fr: 1:100-500; IF: 1:100-500 |
| 抗体种类 | Monoclonal |
| 宿主来源 | Mouse |
| 亚细胞定位 | Golgi apparatus, trans-Golgi network membrane; Peripheral membrane protein. Note=Interaction with ATG14 promotes translocation to autophagosomes. Expressed in dendrites and cell bodies of cerebellar Purkinje cells. |
| 组织特异性 | Ubiquitous. |
| 构建方式 | Hybridoma Monoclonal Antibody |
| 纯化方式 | Protein G purified |
| 性状 | Liquid |
| 缓冲液 | 0.01M TBS (pH7.4) with 1% BSA, 0.02% Proclin300 and 50% Glycerol. |
| 浓度 | 1 mg/mL |
| 研究背景 | Beclin 1 is the first identified mammalian gene to mediate autophagy and also has tumor suppressor and antiviral function. Autophagy, a process of bulk protein degradation through an autophagosomic lysosomal pathway, is important for differentiation, survival during nutrient deprivation, and normal growth control, and is often defective in tumor cells. Beclin 1 was originally isolated in a yeast two hybrid screen to identify Bcl 2 binding partners and maps to a tumor susceptibility locus on human chromosome 17q21 that is frequently monoallelically deleted in human breast, ovarian and prostate cancer. Beclin 1 encodes an evolutionarily conserved 52kDa coiled coil protein that is expressed in human muscle, epithelial cells and neurons. |
| 免疫原 | KLH conjugated synthetic peptide: human Beclin 1 |
| 抗原种属 | Human |
| 基因名称 | BECN1 |
| 基因ID | |
| 蛋白名称 | Beclin-1 |
| Uniprot ID | |
| 研究领域 | Signal Transduction,Tumor suppressors,Autophagy,Tumor Suppressors,Autophagy and mitophagy,Host Immune Response |
| 功能 | Plays a central role in autophagy. Required for the abcission step in cytokinesis. May play a role in antiviral host defense. Protects against infection by a neurovirulent strain of Sindbis virus. |
| 分子量 | Theoretical: 50 kDa. |
| 储存方式 | Store at -20°C or -80°C for 12 months. Avoid repeated freeze-thaw cycles. |
| 运输方式 | Shipping with blue ice. |